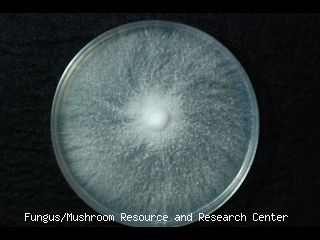

Taxonomic information
- TUFC No.
- 14556
- Division
- Basidiomycota
- Class
- Agaricomycetes
- Subclass
- Order
- Polyporales
- Fungus Name
- Neofavolus alveolaris (DC.) Sotome & T. Hatt.
- Reception Name
- Polyporus alveolaris
- Synonym
- Polyporus alveolaris (DC.) Bondartsev & Singer
Information of deposit, history of strain et al.
- Date of deposit
- 2011/04/01
- Registered by
- K. Sotome
- Depositer name
- K. Sotome
- Affiliation
- FMRC
- History
- <- T. Hattori (FFPRI, Kansai, 7.7-2)
- Former names
- As Polyporus alveolaris until 2012 Nov.
- Other Strain no.
- 7.7-2
Information of collector, source et al.
- Collected by
- T. Hattori
- Affiliation
- FFPRI, Kansai
- Date
- 2010/07/07
- Identified by
- T. Hattori
- Affiliation
- FFPRI, Kansai
- Date
- 2010/07/07
- Isolated by
- T. Hattori
- Affiliation
- FFPRI, Kansai
- Date
- 2010/07/07
Collected location
- Locality
- Sannokou, 700-800 m alt., Kawakami-mura, Nara Pref., Japan
Information of voucher specimen
- Specimen No. (TUMH)
- 50002
Photo(s)
Sequence information
- Sequenced region 1
- ITS1-ITS2
- Sequence Data 1
- >14556_its_KO GTAAAAAGTCGTAACAAGGTTTCCGTATTTGAACCTGCGGAAGGATCATTATCGAGTTTTGAATCGGGGTTGTAGCTGGCCTTTCGGGGCATGTGCACGCCCTGCTCAATCCACTCTACACCTGTGCACTTATTGTGGGTTTCGGGGGGCTTTTTGCCACTCGTACCTATGTTTATTTACAAACGCTTCAGTAAAAGAATGTGTATTGCGATAACGCATCTATATACAACTTTCAGCAACGGATCTCTTGGCTCTCGCATCGATGAAGAACGCAGCGAAATGCGATAAGTAATGTGAATTGCAGAATTCAGTGAATCATCGAATCTTTGAACGCACCTTGCGCTCCTTGGTATTCCGAGGAGCACGCCTGTTTGAGTGTCATGAAATCATCAACTTATAAGCCTTTCATGGGTCTATAAGCTTGGACTTGGAGGCCTGTCGGCGGTCAACGTCGGCTCCTCTCAAATGTATTAGCTTGGTTCCTTGCGGATCGGCTCCCGGTGTGATAATGTCTACGCTGTGACCGTGAAGCGTTTGGCGAGCTTCTAATCGTCTCGTGAGAGACAGCTTCATTGACTCTGACCTCAAATCAAGCGGGACTACCCGCTGAACTTAAGCATATCAATA
Unauthorized copying and replication of the contents of this site, text and images are strictly prohibited.
Reference(s)
- Reference 1
- Sotome, K. , Akagi, S., Lee, S., Ishikawa, N.K. and Hattori, T.. 2013. Taxonomic study of Favolus and Neofavolus gen. nov. segregated from Polyporus (Basidiomycota, Polyporales). Fungal Diversity. 58: 245-266
Additional information
- Biosafety level
- L1
- Physical containment
- P1
- Medium
- MA
- Incubation temp.
- 25 ℃
- Comment
- AB735969 (ITS), AB735947 (LSU rRNA D1/D2 region)
- Date of released
- 2013/08/28
- Date of last modified
- 2021/08/03